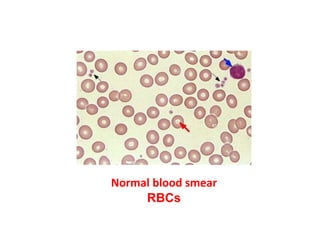
Normal blood smear
RBCs
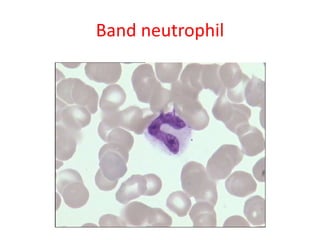
Band neutrophil
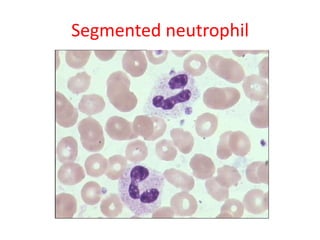
Segmented neutrophil
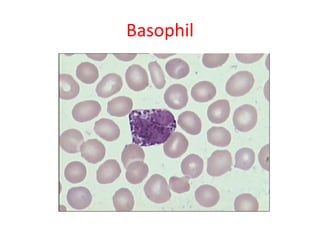
Basophil
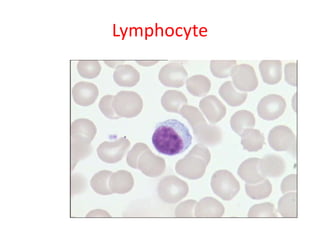
Lymphocyte
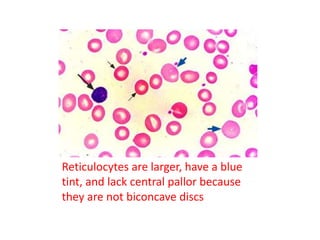
Reticulocytes are larger, have a blue
tint, and lack central pallor because
they are not biconcave discs
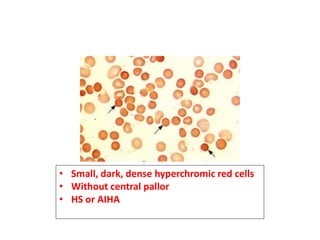
• Small, dark, dense hyperchromic red cells
• Without central pallor
• HS or AIHA
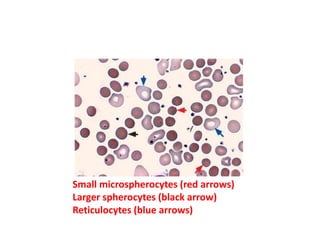
Small microspherocytes (red arrows)
Larger spherocytes (black arrow)
Reticulocytes (blue arrows)
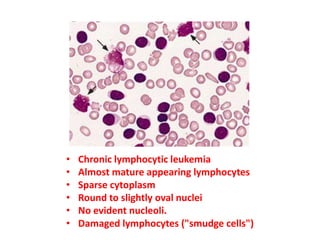
• Chronic lymphocytic leukemia
• Almost mature appearing lymphocytes
• Sparse cytoplasm
• Round to slightly oval nuclei
• No evident nucleoli.
• Damaged lymphocytes ("smudge cells")
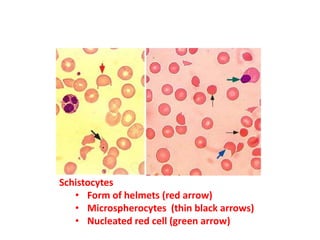
Schistocytes
• Form of helmets (red arrow)
• Microspherocytes (thin black arrows)
• Nucleated red cell (green arrow)
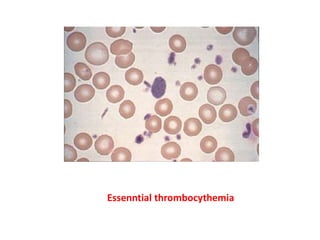
Essenntial thrombocythemia
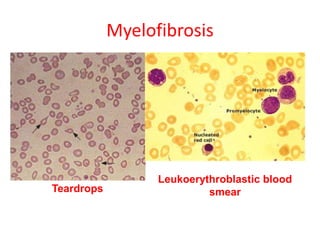
Myelofibrosis
Leukoerythroblastic blood
smearTeardrops
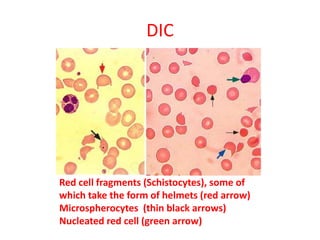
Red cell fragments (Schistocytes), some of
which take the form of helmets (red arrow)
Microspherocytes (thin black arrows)
Nucleated red cell (green arrow)
DIC
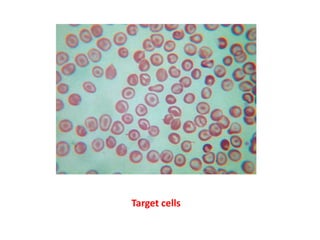
t
Target cells
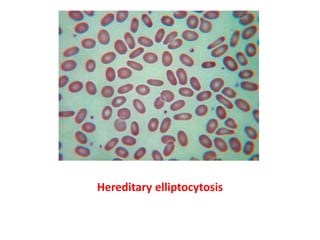
Hereditary elliptocytosis
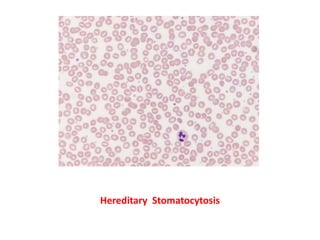
Hereditary Stomatocytosis
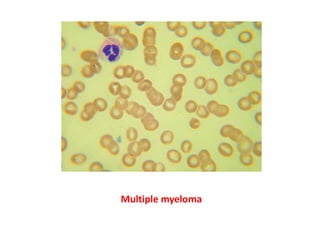
Multiple myeloma
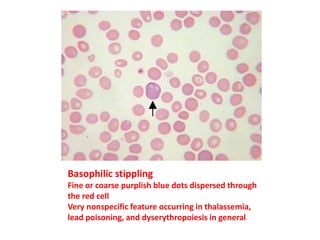
Basophilic stippling
Fine or coarse purplish blue dots dispersed through
the red cell
Very nonspecific feature occurring in thalassemia,
lead poisoning, and dyserythropoiesis in general
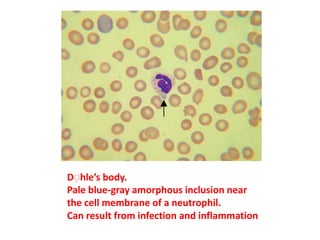
Dِ hle’s body.
Pale blue-gray amorphous inclusion near
the cell membrane of a neutrophil.
Can result from infection and inflammation
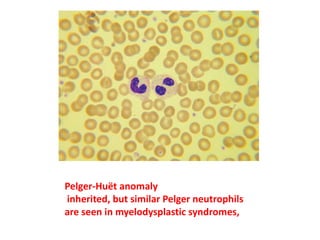
Pelger-Huët anomaly
inherited, but similar Pelger neutrophils
are seen in myelodysplastic syndromes,
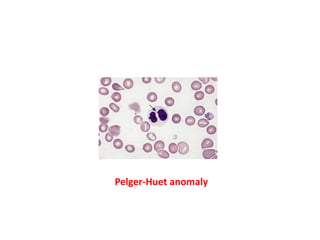
Pelger-Huet anomaly
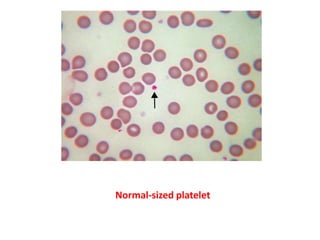
Normal-sized platelet
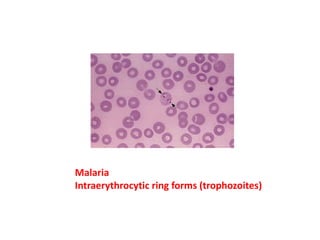
Malaria
Intraerythrocytic ring forms (trophozoites)
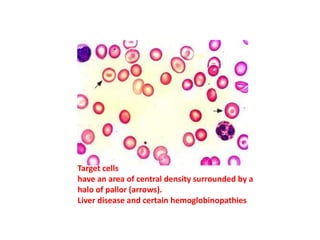
Target cells
have an area of central density surrounded by a
halo of pallor (arrows).
Liver disease and certain hemoglobinopathies
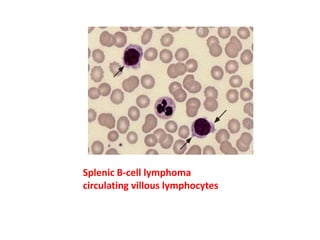
Splenic B-cell lymphoma
circulating villous lymphocytes
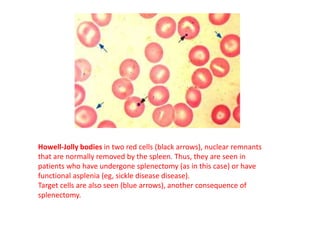
Howell-Jolly bodies in two red cells (black arrows), nuclear remnants
that are normally removed by the spleen. Thus, they are seen in
patients who have undergone splenectomy (as in this case) or have
functional asplenia (eg, sickle disease disease).
Target cells are also seen (blue arrows), another consequence of
splenectomy.

The document provides a detailed evaluation of peripheral blood smear findings, highlighting various blood cell types such as red blood cells, white blood cells, and their characteristics in normal and pathological conditions. It discusses specific abnormalities associated with anemia, leukemia, infections, and other hematological disorders, illustrated with descriptions of cell morphology and features. Additionally, it mentions diseases like myelofibrosis, sickle cell anemia, and lead poisoning, including relevant diagnostic features observed under a microscope.